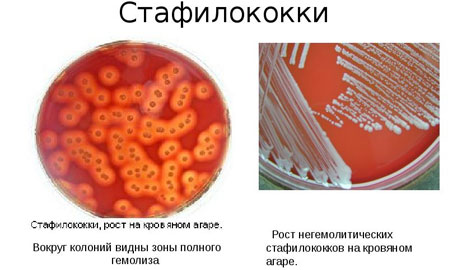

Як правильно лікувати хвороби органів дихання у дітей?
Органи дихання дитини нерідко піддаються . Найчастіше патологічні процеси розвиваються під впливом активації стафілококів і стрептококів. Нерідко до порушень в роботі дихальної системи призводить алергія.
Серед факторів мають значаться не тільки анатомічні особливості органів дихання у дитячому віці, а і несприятлива зовнішня середовище, гіповітаміноз. Сучасні діти з помітною регулярністю не дотримуються режиму дня і неправильно харчуються, що позначається на захисних силах організму і в подальшому призводить до захворювань.
Погіршити ситуацію може відсутність загартовуючих процедур.
Звичайно, прогулянки по морозу в розстебнутій куртці і без шапки не додають здоров’я, однак не це є основною причиною розвитку захворювань дихальних шляхів у дітей. Переохолодження лише призводить до звуження капілярів і зниження імунітету.
Респіраторні захворювання в основному передаються повітряно-крапельним шляхом або через брудні руки. Вони можуть вражати верхні дихальні шляхи і приводити до отиту, синуситу або ангіні. Якщо інфекція поширюється на нижні дихальні шляхи, розвиваються пневмонії і бронхіти.
Часто винуватцем захворювання стають бактерії, зокрема стрептококи, стафілококи і гемофільна паличка. Але не рідше медики мають справу і з вірусами, в першу чергу – з вірусом грипу. Дуже часто на тлі вірусного респіраторного захворювання виникає ускладнення у вигляді бактеріальної інфекції.
Головне засіб в боротьбі з бактеріальними інфекціями дихальних шляхів у дітей і дорослих – це антибіотики. Однак батьки зазвичай ставляться до них з підозрою. Навколо антибіотиків існує величезна кількість міфів і помилок.
А все тому, що люди часом дуже слабо собі уявляють, як ці засоби працюють. Спробуємо розібратися в тому, що ж являють собою антибіотики, навіщо їх призначають і чи можуть вони допомогти вилікувати респіраторні захворювання у дітей.
Міф №1. Антибіотики викликають алергію
Це не зовсім міф – алергічна реакція дійсно можлива. Але в арсеналі медицини дуже багато різних типів антибіотиків. І якщо один препарат конфліктує з імунною системою пацієнта, лікар негайно підбере інший.
Міф №2. Антибіотики знищують імунітет
Цей міф не має під собою ніяких підстав. Немає жодного дослідження, яке доводило б, що антибіотики послаблюють захисні сили організму. А ось запущені хвороби органів дихання у дітей, дійсно, можуть призвести до пригнічення імунітету і частих повторних застуд.
Міф №3. Антибіотики вбивають все живе
Це теж неправда. Більше того – антибіотики не вбивають абсолютно всі шкідливі бактерії разом. Антибіотики – це не засіб масового ураження, вони діють дуже вибірково.
Кожне засіб призначений для впливу на певний тип бактерій, і те, що допоможе при стрептококової інфекції, не допоможе при зараженні іншої. Плутанина відбувається від того, що більшість антибактеріальних засобів називають «антибіотиками широкого спектру дії», і людям непосвяченим здається, що такі ліки повинні вбивати безліч типів бактерій.
Антибіотики постійно вдосконалюються, розробляються сучасні, ще більш безпечні препарати, що випускаються нові зручні лікарські форми, наприклад, таблетки, що диспергуються, які розчиняються у воді, що значно полегшує їх прийом.
Антибіотики – це єдиний відомий медицині ефективний спосіб боротьби з бактеріальними інфекціями, і ніякої чай з малиною їх не замінить.
Статистика стверджує, що захворювання органів дихання у дітей є найбільш частою причиною звернення за медичною допомогою. Їх частка становить приблизно 70% в структурі загальної дитячої захворюваності.
Чому саме дитячі дихальні шляхи схильні до захворювань? Які відділи уражаються частіше? Що необхідно знати, щоб уберегти малюка від важких, часом смертельних ускладнень? Ці питання задають лікарям дуже часто.
Дихальні шляхи дитини повністю дозрівають до початку пубертатного періоду. До цього часу існують відмінності дихальної системи дітей і дорослих людей. Основні особливості у маленького пацієнта наступні:
- Носові ходи дитини звужені, а нижній носовий хід майже відсутній до 4 років.
- Слизова носа ніжна, багата судинами, які при запаленні розширюються.
- Лімфоїдна тканина носоглотки більш розвинена, часто гіпертрофована, що утруднює дихання.
- Гортань і голосова щілина звужені, зв’язки вкорочені.
- Легенева тканина має підвищену щільність.
- Глибина дихання менше.
- Дихальна мускулатура розвинена слабо.
- Фізіологічно частота дихальних рухів підвищена.
- Характер дихання у новонароджених нестійкий.
- Бронхи частіше схильні до звуження просвіту порівняно з дорослими.
Це є передумовами до частих простудних захворювань верхніх дихальних шляхів, бронхіту і пневмонії.
У порожнині носа при нормальному носовому диханні здійснюється постійний контакт організму з навколишнім повітряним середовищем. При наявності різних агресивних зовнішніх факторів слизова оболонка дихальних шляхів піддається впливу мікробів, хімічних речовин, вірусів, різних алергенів і інших негативних факторів. В результаті чого розвивається запалення в тій чи іншій області верхніх дихальних шляхів.
Як правило, зростання захворюваності відзначається в осінньо-весняний період. Саме в цей час може відзначатися переохолодження, зниження імунітету і в умовах високого контакту в дитячих організованих установах вони стають ключовими факторами у розвитку запальних захворювань.
Інкубаційний період становить кілька діб. Починається захворювання гостро, дитина стає млявим, слабким, відзначається зниження апетиту, а в деяких випадках дитина і зовсім відмовляється від їжі, відзначається підйом температури до фебрильних цифр.
Діти дошкільного та шкільного віку можуть поскаржитися ще на запаморочення і втомлюваність. В кінці першої доби з’являється першіння в горлі, спостерігається чхання, і в кінці 2-х діб відзначаються рясні слизові виділення з носа, частий сухий кашель , який потім стає вологим.
Трахеїт — запальне захворювання дихальних шляхів з переважним ураженням слизової оболонки трахеї. Часто поєднується із запаленням бронхів. Запальна реакція супроводжується набряком слизової оболонки трахеї з підвищенням виділення в’язкого слизового секрету, гнійного характеру. Основний симптом — кашель, що посилюється вранці.

Пневмонія — це запалення легенів, що викликається різними бактеріями. Це захворювання органів дихальних шляхів супроводжується розвитком запального процесу в легеневій тканині з переважним ураженням респіраторних відділів легень (альвеол). Нерідко запальний процес поширюється і на судинну систему легенів.
Пневмонія може бути самостійним захворюванням або розвиватися як ускладнення інших хвороб (серцево-судинних), операцій, травм.
Сприятливі фактори для запалення легенів -переохолодження (особливо в умовах підвищеної вологості), висока загазованість, фізична і розумова перевтома, перенесені захворювання легенів, недостатнє харчування, куріння.
Зазвичай пневмонія починається з гарячкового різкого ознобу і підвищення температури до 39-40°С, болі в грудній клітці, що посилюється при кашлі та глибокому диханні. Кашель у перші добу сухий, потім з’являється тягуча, важко відходить мокротиння, іноді містить прожилки крові. У хворого відзначаються слабкість, пітливість (особливо вночі), задишка.
За перебігом розрізняють гострі і хронічні запалення легенів.
Кашель зазвичай виникає від подразнення слизової оболонки дихальних шляхів при запальному процесі. Це один з основних ознак захворювання органів дихання. Іноді може виникати збудження кашльового центру в мозку без подразнення дихальних шляхів. Це так званий нервовий кашель при страху, сумні і пр.
Розрізняють кашель сухий і вологий.
В якості відхаркувальних засобів при бронхіті і пневмоніях використовують наступні рослини: ялівець звичайний, осоку волохату, буркун лікарський, конюшина лучна, фіалку триколірну, дягель лікарський, багно болотний, верес звичайний, мати-й-мачуху, чебрець звичайний, м’яту перцеву (зовнішньо), подорожник великий, оман. Послаблюють кашель сосна звичайна (інгаляції), росичка, мак снодійний.
У клінічній практиці існує безліч класифікацій кашлю; у практичному значенні важливо визначити кашель з його основними клінічними характеристиками.
За характером:
- непродуктивний (сухий) кашель, який не приносить полегшення і стомлюючий хворого, характерний для гострого бронхіту і ларинготрахеїту, плевриту і пневмонії, відзначається при коклюші, раку легенів та інших серйозних захворюваннях дихальних шляхів.
- продуктивний (вологий) кашель сприяє видалення небажаного вмісту бронхів (гною, слизу) у вигляді харкотиння і свідчить про наявність запального процесу з активною ексудацією в бронхах та/ або легеневої тканини.
За часом виникнення або ухудшенияПри пневмонії і бронхіті кашель турбує хворого людини весь день, а до вечора або вночі посилюється. Такий кашель може свідчити також про захворювання на бронхіальну астму (особливо якщо напад закінчується відходженням великої кількості склоподібної мокротиння).
Ранковий кашель переважно спостерігається при хронічних запаленнях дихальних шляхів, у тому числі бронхоектатичної хвороби; в окрему клінічну форму виділяють «ранковий кашель курця».

Причина такого кашлю у тому, що за ніч у дихальних шляхах накопичується мокрота, яка вранці при зміні положення тіла переміщується, подразнюючи рецептори, — і тому виникає потреба відкашлятися і звільнити бронхи.
Особливості дихальної системи у дитячому віці
Захворювання органів дихання у дітей протікають з деякими особливостями. Це пояснюється рядом факторів:
- вузькістю носових ходів і голосової щілини;
- недостатньою глибиною та підвищеною частотою дихання;
- малої легкістю і підвищеною щільністю легенів;
- слабкою розвиненістю дихальних м’язів;
- нестійким дихальним ритмом;
- ніжністю слизової оболонки носа (багата кровоносними судинами і легко набухає).
У новонароджених, частіше у жінок, народжених раніше покладеного терміну, зустрічаються вроджені вади розвитку, що зачіпають окремі частки або повністю легке. Розрізняють:
- Агенезию.
- Аплазії.
- Гіпоплазію легені.
При агенезії спостерігається відсутність бронхів і легенів, при аплазії збережена кукса бронха, але немає легеневої тканини. Гіпоплазія характеризується недорозвиненням бронхів і легені. Прогноз при вроджених дефектах серйозний, часто є поєднання з іншими вадами розвитку.
Ателектази легенів
У недоношених новонароджених часто зустрічаються ателектази легенів – ділянки не розправилася або спавшейся після першого вдиху легеневої тканини. Це пов’язано з незрілістю дихального центру немовляти, а також з недостатнім виробленням сурфактанту, особливої речовини, що утримує альвеоли в розправленому стані.
При відсутності інфекції ателектази в межах сегмента легені розправляються протягом декількох днів, розсіяні – за місяць. Дитина знаходиться в кювезі, проводиться подача кисню, медикаментозна терапія, за показаннями-штучна вентиляція легень або допоміжне дихання.
У пологах відразу і через 5 хвилин після народження стан новонародженого оцінюють за шкалою Вірджинії Апгар, одним із критеріїв якої є оцінка дихання. Якщо ні голосного крику, немовля не дихає або є слабкі поодинокі вдихи, то говорять про наявність у дитини асфіксії.
Вона виникає гостро в процесі пологів, наприклад, при вузлах обвитті пуповини або петлею пуповини в області шиї дитини. Чи буває продовженням хронічного кисневого голодування плоду під час вагітності, наприклад, при анемії у матері.
Однією з причин асфіксії можуть бути природжені бронхоектази. Це мішечкуваті розширення бронхів. При невыраженных одиничних бронхоэктозах клініки не спостерігається, але у дитини є схильність до простудних захворювань у подальшому. При важкій формі в першу добу настає смерть від асфіксії.
Грізна патологія – вроджений інтерстиціальний фіброз. Причини його не вивчені. При ньому відбувається здуття, потовщення або стоншування перегородок усередині легені. Симптоми дихальної недостатності починають проявлятися в перший місяць після народження.
Серед недоношених новонароджених частою причиною смерті є хвороба гіалінових мембран. Суть захворювання в тому, що на внутрішній поверхні повітряних бульбашок – альвеол і тонких бронхіол починає тотально або глыбками відкладатися гиалиноподобное речовина.
Рідко зустрічаються вроджені кісти легенів. На прогноз впливає їх розмір.
Бронхіт — захворювання нижніх дихальних шляхів, що характеризується запаленням бронхів з переважним ураженням їх слизової оболонки. Бронхіт як захворювання дихальної системи є одним з найбільш частих діагностованих станів. Нерідко протікає при одночасному ураженні верхніх дихальних шляхів.
Найбільш часті симптоми бронхіту — загальна слабість, озноб, підвищення температури тіла та головним чином кашель.
Це гостре захворювання дихальної системи виникає в результаті вірусної або бактеріальної інфекції (грип, кір, кашлюк та ін), дії токсичних речовин, внаслідок куріння та ін Велике значення у виникненні бронхіту та його рецидивів мають стан організму в цілому, його опірність, що змінюється під впливом перенесених захворювань, несприятливих умов праці та побуту, переохолодження, шкідливі звички (алкоголь і ін) і т. п.
Розрізняють гостру і хронічну форми бронхіту.
Для профілактики бронхіту першорядне значення має ретельне і своєчасне лікування нежиті, тонзиліту та інших видів осередкової інфекції, важлива роль відводиться загартовуванню організму. Для лікування найчастіше необхідно застосовувати протизапальні, відхаркувальні і протикашльові засоби.
Далі наведені найбільш популярні народні засоби для лікування легенів і бронхів, представлені настоянками на травах і продукти бджільництва.
Інгаляції настоянкою прополісу.
При бронхіальній астмі для лікування легенів народними засобами роблять інгаляції 10-15%-ной спиртової настойкою прополісу.
Настоянка полину гіркого.
- 20 г полину заливають 0,5 л горілки і настоюють не менше доби в темному прохолодному місці. Приймають по 1 столовій ложці 3 рази на день до їди і перед сном як відхаркувальний і противокашлевого засоби при запаленні легенів.
- Наполягають квітучі верхівки полину на 70%-ном спирті (1 : 10) 2 тижні в темному місці, проціджують і приймають по 20-40 крапель 3 рази на день до їжі, запиваючи соком або киселем, при туберкульозі легень. Залежно від стану дозу народного засобу для лікування легенів можна збільшити до 1 чайної ложки.
Настоянка коріння бедринця ломикамені.
40 г коренів рослини наполягають на 100 мл 70%-ного спирту або горілки протягом 8 днів у темному шафі, проціджують і віджимають.
Приймають це народний засіб для лікування легенів і бронхів по 30 крапель 4-5 разів на день з 1 столовою ложкою води. Застосовується це старовинне народне засіб від бронхіальної астми.
Для лікування хвороб легенів народними засобами застосовують настої з різних лікарських зборів трав. Далі представлені рецепти, які використовуються в лікуванні хронічної обструктивної хвороби легенів народними засобами і надають виражену позитивну динаміку.

Настоянка кореня терну.
Корінь терну подрібнюють і поміщають у півлітрову пляшку, яку заливають доверху горілкою і закривають пробкою. Настоюють у теплому місці як можна довше.
Приймають по 1 десертній ложці 3 рази в день перед їжею до поліпшення самопочуття при хронічної обструктивної хвороби легень.
Медова настоянка шишок туї.
У трилітрову банку вливають 4 склянки меду і 2 л горілки, місце, що залишилося заповнюють дрібно подрібненими шишками туї, зібраними в кінці літа. Готову суміш ставлять у тепле місце на тиждень, не забуваючи щодня збовтувати вміст банки.
Приймають лікувальну настоянку 3 рази в день по 1 столовій ложці при хронічної обструктивної хвороби легень. Курс лікування розрахований на 1 місяць, далі роблять 10-денну перерву, після чого при необхідності курс повторюють.
Для лікування запалення легенів народними засобами застосовуються натуральні природні антибіотики. Найбільший ефект в лікуванні запалення легенів народними засобами у дорослих дають продукти бджільництва і настойки з ними.
Медова настоянка з соком алое.
Змішують сік алое і меду (по 1 склянці), заливають 250 мл медичного спирту і настоюють протягом 5 днів у темному місці.
Приймають внутрішньо при запаленні легенів по 1 столовій ложці 3 рази в день до їди, поки не наступить повне одужання.
Настоянка свіжих березових бруньок.
Свіжими березовими бруньками, у яких проклюнулися листочки, наповнюють пляшку, заливають доверху горілкою і настоюють 7-10 днів. Приймають по 5-7 крапель, розбавлених водою, 3 рази на день при пневмонії.
Для лікування легенів народними засобами в домашніх умовах важливо попередньо пройти обстеження у лікаря і отримати точний діагноз. Потім можна успішно вибрати рецепт для лікування захворювань легенів народними засобами з представлених тут способів.
Солодка настойка кедрових горіхів.
Стакан подрібнених кедрових горіхів змішують зі склянкою цукру і заливають 0,5 л горілки. Настоюють протягом 14 днів в темному місці, щодня збовтуючи. Приймають всередину при бронхіті по 1 чайній ложці 3 рази на день, поки не наступить повне одужання.
Настоянка насіння моркви.
1 столову ложку насіння моркви засипають в скляну пляшку, заливають горілкою і настоюють протягом тижня в теплому місці. Готову настоянку проціджують і приймають всередину при бронхіті по 1 столовій ложці 3 рази в день в проміжках між прийомами їжі, поки не наступить повне одужання.
Настоянка шкаралупи волоського горіха.
Подрібнену молотком шкаралупу від 14 горіхів заливають 0,5 л горілки і настоюють протягом тижня в теплому і темному місці. Готову настоянку проціджують і ставлять на зберігання в холодильник. Приймають внутрішньо по 1 столовій ложці вранці натщесерце, поки настоянка не закінчиться, при бронхіті, кісті яєчника, відкладеннях солей, зобі.
Настоянка квіток бузку
Літрову банку доверху заповнюють квітами бузку, заливають горілкою і настоюють протягом 10 днів. Приймають внутрішньо на ніч, вливаючи 10 мл настойки, в склянку міцно завареного чаю. П’ють маленькими ковтками для лікування бронхіту.
Вітамінна настоянка з медом і алое.
Змішують рівні об’єми соку червоного буряка, чорної редьки, цибулі, лимона, журавлини, алое, а також меду, цукрового піску і 96%-ного спирту. Все ретельно перемішують і ставлять на зберігання в холодильник.
Сік алое активний відносно різних груп мікробів: стафілокока, стрептокока, кишкової, дифтерійної і черевнотифозної палички.
Для отримання соку алое використовують рослини не молодше двох років. Зрізають великі нижні і середні листки, промивають їх кип’яченою водою, потім розрізають на дрібні шматочки і вичавлюють сік через 2 шари марлі (можна пропустити через м’ясорубку або віджати за допомогою соковижималки).
Особливо цінується так званий биостнмулированный сік (метод запропонований академіком В. П. Філатовим). Для його отримання промиті листя алое кладуть на тарілку, прикривають папером і поміщають в холодильник на 12-15 днів.
У таких несприятливих для рослини умовах, коли починають згасати всі життєві процеси в клітинах алое відбувається утворення особливих речовин, які отримали назву біогенних стимуляторів; вони збуджують згасаючу життєдіяльність клітин.
Характеристика препаратів бронхонал і солодка
Бронхонал ЭДАС-104 (ЭДАС-904 гранули) є протизапальну, відхаркувальну і бронходилятирующим засобом. За рахунок поєднання гомеопатичних компонентів, що входять до його складу (Ехінацея, Ипекакуана, Пульсатілла і Антимониум тартарикум), препарат ефективно лікує респіраторні захворювання з кашлем і рясної трудноотделяемой мокротою, а також сприяє відновленню імунних процесів організму і підвищує опірність організму (особливо в дитячому і літньому віці).
- знімає запалення і набряк слизової носоглотки;
- допомагає при сухому спазматическом кашлі з нудотою і блюванням;
- зменшує экспираторную задишку, напади задухи, полегшує утруднене дихання;
- сприяє зняттю осиплості голосу і болючою сухості в горлі.
У інтегративної терапії кашльового синдрому засоби, що стимулюють відходження і просування мокротиння, широко представлені фітопрепаратами (фіалка триколірна, мати–й–мачуха, алтей, подорожник, материнка, чебрець, термопсис, чебрець), і особливо ефективна в цьому відношенні Солодка, або Лакриця (Glycyrrhíza).
Солодка своїми видатними цілющими властивостями зобов’язана високому вмісту біологічно активних речовин. До її складу входять: аскорбінова кислота, мінеральні речовини, вуглеводи, полісахариди (глюкоза, фруктоза, мальтоза, сахароза), органічні кислоти, смоли, стероїди, дубильні речовини, флавоноїди, кумарини, алкалоїди, вищі жирні кислоти.
Солодовий корінь як лікувальний засіб використовували в своїх лікарських композиціях Гіппократ і Гален; високо оцінював це лікарська рослина середньовічний лікар і вчений-енциклопедист Абу Алі ібн Сіна (Авіценна).
Китайські і тибетські лікарі використовували екстракт або відвар солодки для нейтралізації дії багатьох отрут (гліциризин, що входить до складу лакричного кореня, нейтралізує дію токсинів) і додавали його в різні ліки для посилення їх дії і для поліпшення смаку.
Солодка активно посилює виділення слизу і мокротиння, тому вона застосовується для лікування сухого наполегливої кашлю при бронхіті і пневмонії, а протизапальні та детоксикаційні властивості дозволяють використовувати її препарати при гарячкових станах.
Ще одна чудова властивість солодки – вона пролонгує лікувальну дію інших препаратів, посилюючи їх терапевтичний ефект, а солодкий смак кореня робить прийом ліків більш комфортним.
Солодка благотворно впливає на біохімічні процеси, що протікають в організмі: регулює водно-сольовий обмін, має тонізуючу дію, сприяє виробленню гормонів кори надниркових залоз, недостатність функцій якої часто супроводжує важкі запальні та інфекційні захворювання.
Корінь солодки має протизапальну дію, вираженими обволікаючим і відхаркувальну властивості, тому комплекс біологічно активних речовин натурального походження на його основі Солодка ЭДАС (таблетки) незамінний при лікуванні гострих і хронічних бронхітів, пневмонії, емфіземи легенів і інших респіраторних захворювань і показаний для полегшення кашлю і стимуляції імунної системи організму.
Оскільки внаслідок інфекційного ураження при респіраторних захворюваннях у хворих завжди відзначається інтоксикація, то паралельно основного лікування з самого початку хвороби протягом 2 тижнів показано проводити детоксикацію за допомогою препарату Карсат ЭДАС-136 краплі (ЭДАС-936 гранули).
Крім того, за свідченнями призначається антистресова терапія —
Пасифлора ЭДАС-111 краплі (ЭДАС-911 гранули); сироп Пассамбра ЭДАС-306 рекомендується пацієнтам дитячого та похилого віку.
Чи знаєте ви, що……сухий кашель як побічна дія виявляється у 20% хворих, які приймають β-блокатори та інгібітори АПФ (ангіотензинперетворюючий фермент), які часто призначаються при лікуванні артеріальної гіпертензії та хронічної серцевої недостатності.
Цікаво знати, що……у результаті дослідження, проведеного за підтримки Європейського респіраторного товариства (ERS), з’ясувалося, що близько 95% випадків тривалого кашлю обумовлені хронічним бронхітом (найбільш часта причина — куріння), ХОЗЛ (хронічне обструктивне захворювання легень, бронхіальну астму і бронхоектатичної хворобою.
Чи знаєте ви, що……у пацієнтів з рясним (більше 250 мл на день), який посилюється при зміні положення тіла, відходженням мокротиння при кашлі, найчастіше діагностується бронхоектатична хвороба.
Відомо, що……внаслідок детоксикаційних властивостей солодки її препарати застосовуються для відновлення організму після радіаційного ураження та хіміотерапії, а в США і Японії використовуються для лікування тютюнової залежності.
Чи знаєте ви, що……комплексні гомеопатичні лікарські засоби «ЭДАС» створені на основі натуральних компонентів, не мають побічних дій і не викликають звикання;
сумісні з іншими лікувально-профілактичними засобами. Відпускаються без рецепта лікаря та показані до застосування в будь-якому віці. Доказом перерахованих якостей є 20-річний досвід їх успішного застосування в практичній медицині.
Симптоматика
Незважаючи на існування характерних для кожного окремого захворювання дихальної системи дитини ознак, лікарями виділяються загальні:
- (обов’язковий симптом, своєрідна захисна реакція організму);
- задишка
(сигналізує про нестачу кисню); - мокрота
(особлива слиз, що виробляється у відповідь на присутність подразників); - носові виділення
(можуть бути різного кольору і консистенції); - утруднене дихання;
- підвищення температури
(сюди ж можна віднести загальну інтоксикацію організму,що представляє собою сукупність біологічних реакцій організму на інфекцію).
Народні засоби для лікування легенів і бронхів
- Тантум Верде.
- Гексорал.
- Дигідрогеноцитратпісля.
- Інгаліпт.
Усунути больові відчуття, а також позбутися від неприємного першіння допомагають також і льодяники, які продаються в аптеках:
- Фалиминт.
- Доктор МОМ.
- Травісил.
- Коделак.
При сухому кашлі хворого нерідко прописують мікстури, які позитивним чином впливають на слизову оболонку верхніх дихальних шляхів:
- Гербионе.
- Пертуссине.
- Бронхикуме
- Супримо Бронхо.
Усунути такий симптом також допомагають краплі рослинного походження Геделикс. Приймати всі вищевказані препарати для лікування захворювання слід з обережністю. Особливо це стосується дітей віком до дванадцяти років, а також вагітних жінок і годуючих мам.
- Марлю або бавовняну тканину змочити соняшниковою, лляною або оливковою олією і додати до грудній клітці. Накрити її зверху пакетом і загорнутися в теплу пухову шаль. Залишити такий компрес на ніч.
- Розтопити в склянці молока сто грам вершкового масла, додати столову ложку меду і випити теплим. Через брак меду в дану суміш можна насипати невелику щіпку соди. Приймати такий засіб можна кілька разів в день.
- У велику каструлю з окропом висипати пачку соди, накритися з головою щільним ковдрою і дихати ротом. Видихаючи пар через ніс.
- Заварити в рівних частинах листя або сушені плоди малини, материнку і ягоди калини, трохи настояти і приймати по полкружки три рази протягом дня в теплому вигляді.
- У невелику кількість молока додати одну чайну ложку сухого шавлії та довести цей склад до кипіння. Після цього трохи остудити і знову довести до кипіння. Процідити засіб і випити на ніч, обов’язково накрившись після його прийому ковдрою, щоб як слід пропотіти.
Лікування верхнього кашлю має проводитися комплексно, краще, коли будуть задіяні не тільки засоби традиційної медицини, але і народної.
Бронхіальна астма — це хронічне алергічне захворювання дихальних шляхів, що характеризується повторюваними нападами задухи внаслідок спазму бронхів або набряку їх слизової оболонки («астма» в перекладі з грецького означає «задуха», «важке дихання»).
В основі бронхіальної астми лежить підвищена чутливість організму, і особливо тканин бронхів до різних, зазвичай нешкідливим, речовин — алергенів. Напади цього хронічного захворювання верхніх дихальних шляхів можуть виникати і без впливу алергену — у зв’язку зі змінами погоди, охолодженням, негативними емоціями.
Лікування цього захворювання верхніх дихальних шляхів базується на принципах загальної десенсибілізації організму.
Туберкульоз легенів (бугорчатка, сухоти) — це хронічне інфекційне запальне захворювання дихальних шляхів з утворенням специфічних змін, що часто мають вигляд дрібних горбків, переважно в легенях і лімфатичних вузлах, і з схильністю до рецидивуючого перебігу.
Захворювання виникає в результаті попадання в організм туберкульозної палички. Основне джерело розповсюдження туберкульозу — хворий чоловік з відкритою формою туберкульозу. Передача інфекції — повітряно-крапельним шляхом.
Розвитку захворювання сприяють: ослаблення організму в зв’язку з нестачею в їжі повноцінних тваринних білків і вітамінів (вітаміну С); несприятливі умови праці і професійні шкідливості; деякі захворювання (цукровий діабет, хронічний бронхіт, алкоголізм та ін);
Для хворих характерні схильність до застуди, нежиті, катару верхніх дихальних шляхів.
Лікування захворювань дихальних шляхів повинно бути комплексним і включати в себе всі можливі методи і способи, спрямовані на відновлення здоров’я пацієнта. Лікування дихальних шляхів народними засобами в даний час має під собою наукове обґрунтування.
Вітамінна суміш з настойкою коренів хрону
Корінь хрону (100 г) добре миють за допомогою щітки (не очищаючи), дрібно нарізають і заливають 150 мл горілки. Настоюють протягом 24 год.
1 кг моркви і 2-3 лимона подрібнюють у м’ясорубці і розмішують з 1 кг меду.
Настоянку коріння хрону проціджують і змішують з медовою сумішшю. Посуд з сумішшю ставлять в захищене від світла місце, настоюють 3 тижні. Приймають при фіброзі легень 3 рази в день по 1 столовій ложці до одужання. Таку суміш можна застосовувати і в профілактичних цілях.
Настоянка прополісу
20 г подрібненого прополісу заливають в пляшці (або інший скляному посуді з кришкою) 80 мл етилового спирту і настоюють, періодично збовтуючи, протягом 7-10 днів, потім фільтрують і після відстоювання рідку фазу настою приймають всередину по 20 крапель з молоком або водою за 30 хв до їди 3 рази в день протягом 2 місяців при лікуванні фіброзу легенів.
До патологій можуть призвести віруси і бактерії. Відомо, що представлена група хвороб одна з частих причин звернення батьків дитини до педіатра.
Згідно з статистичними даними, в рік дитина дошкільного і молодшого шкільного віку може перенести від 6 до 10 епізодів порушення роботи ВДСП.
Запалення слизової оболонки носа, що виникає на тлі вірусної інфекції
. Поштовхом до розвитку риніту може стати банальне переохолодження, в результаті знижує захисні сили організму.
Ателектази легенів

З захворюваннями з цієї класифікації людина зустрічається дуже часто. Зокрема, ще не було в практиці педіатра жодного випадку, щоб протягом хоча б 1 року дитина жодного разу не поскаржився на нежить. Тому варто розглянути більш докладно хвороби верхніх дихальних шляхів.
Риніт
У дітей будь-якого віку часто доводиться спостерігати симптоми риніту – запалення слизової оболонки носа. Слизова носа стає вхідними воротами для вірусів парагрипу, аденовірусу та інших. Зустріч з патогенами відбувається в дитячих колективах, підтвердженням цього є те, що всім батькам знайома ситуація, коли здоровий малюк хворіє незабаром після початку відвідування дитячого садка.
Симптоми риніту у дитини:
- Спочатку з’являється рідке слизові виділення. Це захисна реакція організму на впровадження вірусу.
- Через деякий час відокремлюване загусає, з’являється закладеність носа. Температура залишається в межах норми.
Тактика батьків при початкових симптомах риніту найчастіше зводиться до активного лікування від крапель в ніс судинозвужувальних препаратів до застосування антибіотиків. Який підсумок? Антибіотики не діють на віруси, до судинозвужувальних крапель швидко виникає звикання.
Алгоритм правильних дій батьків при риніті такий:
- Забезпечити рясне пиття і вологе прохолодне повітря в приміщенні, де знаходиться хворий.
- Правильно висякувати ніс у дітей дошкільного віку, а старших дітей навчити це робити самостійно.
- Знати правила закапування в ніс судинозвужувальних засобів.
Якщо з першим пунктом все зрозуміло, то правило высмаркивания носа відомо не всім. Затиснувши обидві норки, дитині радять дути. Це не сприяє виділенню слизу, але може загнати інфекцію в слухову трубу, що закінчиться розвитком отиту.
А якщо слиз все-таки загусла і высмаркивание ускладнене? В носик малюка треба закопувати не антибіотик, не судинозвужувальні краплі, а сольовий розчин, який легко приготувати вдома. На літр кип’яченої води додають 1 чайну ложку кухонної солі. Цю ж воду можна давати пити.
Є чіткі показання до закопування судинозвужувальних крапель:
- На тлі риніту дитина скаржиться на біль у вусі.
- Носове дихання повністю відсутня.
- Носове дихання утруднене помірно, але через рот дихає важко.
- Вдома жарко, дихає поперемінно через ніс і рот з працею.
- Температура понад 38,5, є задишка, ніс закладений.
Це запалення слизової оболонки глотки або мигдалин. Причина запалення – бактеріальна або вірусна інфекція. Дитину турбує першіння в горлі, подкашливание, болю при ковтанні, можуть бути невеликі підйоми температури. Часто фарингіти виникають як прояви ГРВІ.
При огляді визначається почервоніння, набряк, висипання на задній стінці глотки. На відміну від ангіни і тонзиліт немає збільшення та почервоніння мигдалин. Допомагає відрізнити одне від іншого такий симптом.
Друга важлива відмінність – підйом температури. При стрептококової інфекції або дифтерії виражена температурна реакція, з’являється відразу з початку хвороби. При фарингіті температура невисока, виникає на фоні вже розвилися симптомів.
Гнійний наліт змушує запідозрити бактеріальний фактор.
Якщо мова йде про вірусної етіології, то призначення антибіотиків не виправдано. А ось у разі стрептококової природи захворювання без них не обійтися.
Ларингіт
Це запалення слизової оболонки гортані. У дітей воно виникає на тлі алергій, інфекцій або інгаляцій гарячим паром. При звичайному перебігу ларингіту відзначається підвищення температури, гавкаючий кашель, осиплість або втрата голосу.
Важливий діагностичний момент – при звичайному перебігу ларингіту немає утрудненого дихання. Якщо з’явився цей симптом (на відміну від астми утруднений саме вдих), то мова йде про інфекційному стенозуючому ларингіті, ускладненому крупом. У разі появи утрудненого дихання потрібна швидка медична допомога.
Що треба знати батькам, якщо у дитини виникло таке захворювання органів дихання, стенозуючий ларингіт:
- До приїзду швидкої допомоги слід дитині максимальний спокій, не проявляти паніки, не хвилювати дитини, так як легко неправильними діями можна спровокувати спазм гортані і задуху.
- Важливо забезпечити комфортні умови перебування дитини: температура в кімнаті не вище 18, вологість 50-70%.
- Дитину треба рясно поїти.
- Можна дати жарознижуючі і закапати судинозвужувальні краплі в ніс.
- Аносмія – хвороба, в основі якої лежать розлади нюху. Така патологія може спостерігатися при вроджених дефектах, генетичних аномаліях або після травматичного пошкодження носової перегородки.
- Нежить або риніт – запалення слизової оболонки носа. Виникає як відповідна захисна реакція на впровадження в неї бактерій, вірусів або агентів алергічного походження. Часто є першою клінічною ознакою різних інфекцій: кору, грипу, скарлатини, а також сильного переохолодження.
На початковому етапі риніт характеризується відчуттям закладеності і набряком слизової оболонки носа, потім з’являються рясні виділення, гугнявість. Згодом відокремлюване стає густим слизовим або гнійним і зменшується.
Хронічний нежить проявляється постійною закладеністю, зниженням нюху і мізерними виділеннями з носа.
- Синусит відноситься до гострих респіраторних інфекцій, найчастіше є ускладненням після перенесених вірусних хвороб, таких як грип, скарлатина, кір. Проявляється захворювання запаленням придаткових пазух носа. Симптоми виражаються в підвищенні температури тіла, сильної закладеності з ураженої сторони, головними болями і рясними виділеннями з носа. Для хронічної форми хвороби характерно стертий перебіг.
- Аденоїдит – запалення носової мигдалини, обумовлено розплавленням і зміною складу її тканини. Захворювання проявляється в дитячому віці, частіше всього від 3 до 11 років. Яскравою ознакою хвороби є утруднення дихання і порушення сну у дітей, також можуть спостерігатися погіршення слуху, зміна тембру голосу, головні болі.
- Тонзиліт – набряк і гіперемія глоткових мигдалин. Їх запалення може розвинутися в результаті вірусної або бактеріальної атаки. Для хвороби характерні: висока температура, утруднення і біль при ковтанні, симптоми інтоксикації. Хронічний тонзиліт небезпечний тим, що патологічні токсини, що виділяються при запаленні мигдалин, згубним чином впливають на серцевий м’яз, порушуючи її роботу.
- Заглотковий абсцес розвивається в результаті скупчення гною в підслизової глотки. Це гостре захворювання проявляється різким підйомом температури і сильними болями при ковтанні.
- Фарингіт – запалення глотки. Викликається як інфекційними агентами, так і тривалим вдиханням або заковтуванням дратівливих хімічних речовин. Для фарингіту характерний сухий кашель, біль і першіння в горлі.
- Ларингіт – процес, що розвивається в гортані. Запалення викликається мікроорганізмами, впливами зовнішнього середовища, переохолодженням. Захворювання проявляється сухістю в горлі, захриплістю, спочатку сухим, а потім вологим кашлем.
- Пухлинні процеси розвиваються у всіх відділах верхніх дихальних шляхів. Ознаками новоутворень є постійні болі на боці ураження, кровотечі і загальні астенічні прояви.
Як правильно лікувати хвороби органів дихання у дітей?
Діарея виникає (як правило, абсолютно несподівано) в результаті зараження яким-небудь штамом (сальмонелою або колибактерией), вірусом (гастроентерит) або паразитами (наприклад, амебою), від яких організм прагне позбутися.
Ще однією причиною появи діареї є порушення кишкової флори, яка може бути спровокована прийомом антибіотиків або стресом. Найбільш частим джерелом зараження є заражена бактеріями вода, яка нерідко зустрічається в країнах з жарким кліматом.
Базовий компонент для ароматерапевтичного лікування розлади шлунково-кишкового тракту: майоран (при неврогенном проносі).
Для прийому всередину:
- Перший спосіб дає найбільш швидкий результат: капніть 1 краплю під язик. Уповільнений ефект досягається другим способом, більш повільним: капнути 1 краплю на таблетку з нейтральним вмістом (плацебо) і тримати у роті до повного розчинення.
Для змазування:
- Кожні три години змащуйте 1 краплею область сонячного сплетіння.
Базовий компонент для ароматерапевтичного лікування розлади ШКТ: материнка звичайна (якщо діарея має інфекційний характер).
Для прийому всередину:
- Капніть 1 краплю на таблетку з нейтральним вмістом (плацебо) або кавову ложечку оливкової олії і дер житє в роті до повного розчинення. Повторювати до або після прийому їжі вранці, вдень і ввечері.
Для прийому всередину і масажу змішайте:
- Ефірне масло гвоздикового дерева 1 краплю
- Ефірне масло чебрецю з тианолом 1 краплю
- Ефірне масло чаберу садового запашного 1 краплю
- Ефірне масло коричника китайського 1 краплю 4
- Ефірне масло базиліка 1 краплю
Капніть 2 ка пли суміші на шматочок цукру або чайну ложку оливкової олії і тримати у роті до повного розсмоктування 4 разів на день. Також ви можете змішати цей склад з будь-яким рослинним маслом за вашим вибором (мигдальним, наприклад) і масажними рухами втирати в нижню частину живота і поперек.
Для лікування шлунково-кишкового розлади у дорослих і дітей старше 12 років попросіть фармацевта виготовити желатинові капсули, резистентні до дії шлункового соку, з наступним складом:
- Ефірної олії гвоздикового дерева 10 мг
- Ефірної олії естрагону 10 мг
- Ефірної олії коричника китайського 10 мг
- Ефірної олії фенхеля звичайного 10 мг
- Ефірної олії м’яти бергамотной 10 мг
Протягом 10 днів приймайте 3-4 капсули в день під час кожного прийому їжі. При необхідності повторіть 2-3 р аза і з нтервалом 10 днів.
Додаткові рекомендації:
- Пийте якомога більше води (краще мінеральної), щоб уникнути зневоднення, яке тільки посилить діарею.
- Їжте рис і пийте рисовий відвар.
- Підтримайте кишкову флору ферментами молочнокислих бактерій, які продаються в аптеці. При діареї ці пробіотики посилять захисні функції організму. Вони особливо рекомендуються при затяжній діареї, а також для профілактики подібних явищ під час подорожей. Ефективність профілактики і лікування діареї пробіотиками підтверджена відгуками мільйонів людей, які, повернувшись з поїздки, писали нам листи подяки!
- Уникайте прийому протидіарейний препаратів: заблокувавши вихід, вони тим самим перешкоджають висновку патогенних бактерій. На відміну від протидіарейний препаратів, ефірні олії вбивають бактерії і одночасно припиняють пронос.
- Уникайте жирної їжі та кави (навіть без кофеїну).
Хвороба Крона та геморагічний ректоколит — це два близьких один одному захворювання, походження яких поки невідомо.
Ці захворювання, які проявляються хронічним розладом травлення, погіршенням загального стану організму, сильними болями і появою (в обох випадках) гострого кривавого проносу, вражають багато етнічні групи і можуть виникнути в будь-якому віці.
Велику допомогу в лікуванні цієї хвороби ШКТ надають ефірні олії, які ефективно знімають хворобливі спазми.
Загальні симптоми
Трахеїт може бути гострим і хронічним. У кожної форми хвороби свої симптоми і особливості.
Хвороба заявляє про себе на 3 добу після появи симптомів запалення носоглотки і ураження гортані. Перший симптом гострого трахеїту – субфебрильна гіпертермія. Рідше температура тіла може підніматися до позначки в 38,5 ° Цельсія.
Характерний симптом хвороби – сильний сухий кашель, що не приносить полегшення вночі, і ранковий кашель з відведенням великої кількості харкотиння.
У дітей запалення трахеї проявляється в нападах кашлю, які можуть бути спровоковані сміхом, різким рухом, ковтком холодного повітря.
Незалежно від віку людина при трахеїті починає відчувати першіння в горлі та біль в області грудини. З-за того, що глибокі вдихи провокують болісні напади кашлю, пацієнт починає дихати поверхнево.
Коли в гостре запалення трахеї залучається гортань, тоді у хворого відзначається гавкаючий кашель.
При вислуховуванні дихання пацієнта з допомогою фонендоскопа доктор може чути сухі і вологі хрипи.
Хронічний трахеїт

Хвороба переходить у форму в тому випадку, коли пацієнт не отримав своєчасне лікування при гострому трахеїті. Втім, нерідкі випадки, коли хронічне запалення трахеї розвивається без гострої стадії.
Як правило, подібна патологія відмічається у людей, дуже багато палять і вживають велику кількість алкоголю. Також подібне може траплятися з пацієнтами, у яких є інші хронічні хвороби органів дихання, серця і нирок.
Основним симптомом хронічного трахеїту є кашель. При хронічній формі перебігу хвороби він хворобливий і приходить у вигляді сильних приступів. Вдень людина може зовсім не кашляти, але вночі напади будуть заважати йому заснути. Мокрота при такому кашлі частіше гнійна.
Хронічне запалення трахеї завжди протікає з періодами загострення, під час яких його симптоми стають схожими на симптоматику гострого трахеїту.
Лікарі ділять респіраторні захворювання у дітей і дорослих на дві групи – захворювання нижніх і верхніх дихальних шляхів. Власне, загальноприйнятою кордону між верхніми і нижніми дихальними шляхами не існує.
На респіраторні захворювання у дітей вказують наступні ознаки:
- Закладений ніс, слизові або слизово-гнійні виділення з носа;
- Чхання;
- Кашель – сухий, так і з відділенням мокротиння;
- Біль у горлі, наліт на поверхні мигдалин;
- Збільшення шийних лімфатичних вузлів;
- Підвищення температури тіла (у маленьких дітей вона може підвищуватися швидко і дуже значно, до 40°С);
- Нудота та блювання, викликані інтоксикацією організму.
Якщо ви помітили у дитини ці симптоми, не намагайтеся самостійно поставити діагноз. Відрізнити вірусну інфекцію від бактеріальної, виходячи тільки із симптомів, дуже важко. Виявити збудника хвороби і призначити ефективне лікування можна лише після лабораторної діагностики.
Захворювання верхніх і нижніх відділів дихальних шляхів можуть протікати як у гострій, так і в хронічній формі. При цьому стерта форма перебігу захворювання з малопомітними симптомами може відповідати і гострого, і хронічного процесу.

Якщо при гострому перебігу захворювань дихальних шляхів у дітей симптоми яскраво виражені та викликають занепокоєння батьків, то при хронічному перебігу хвороби ознаки респіраторних захворювань часто ігноруються.
До розвитку ускладнень призводить і самолікування. Найчастіше домашня «терапія» включає в себе засоби, які знімають симптоми, температуру, запалення слизових оболонок і кашель, але ніяк не впливають на причину хвороби – віруси і бактерії. В результаті захворювання в ряді випадків може перейти в хронічну форму.
Нерідко батьки, бачачи, що «народні засоби не допомагають, все ж ведуть дитину до лікаря. Але в таких випадках лікування триває довше, оскільки хвороба вже буває запущена.
Основні симптоми, що вказують на проблеми у системі органів дихання в малюка, зводяться до наступним:
- Утруднене носове дихання.
- Закладеність носа.
- Підвищена температура.
- Підвищення частоти дихання.
- Зменшення глибини дихання.
- Задишка.
- Кашель.
- Відділення мокротиння.
- Зміна кольору шкіри в області носогубного трикутника – поява синюшного відтінку (ціаноз).
Поєднання симптомів змінюється в залежності від залучення в хворобу різних відділів дихальної системи.
До запальних захворювань верхніх дихальних шляхів відносяться інфекції гортані і носоглотки. Як правило, вхідними воротами інфекції є слизова ротоглотки і носа, де осідають віруси, бактерії і потім з потоком крові, а також по лімфатичній системі розносяться по всьому організму. Особливо вразлива категорія – це, звичайно, діти.
Враховуючи анатомо-фізіологічні особливості будови дихальних шляхів дитячого організму і недозрелость всіх ланок імунної системи, розвиток інфекційного процесу може бути блискавичним. Тому, заходам профілактики серед дітей потрібно приділяти особливу увагу.
Яким би типом вірусу не була викликана ГРВІ, при класичній формі захворювання присутні деякі загальні симптоми:
- «общеинфекционный» синдром (дитину морозить, можуть турбувати болі в м’язах, в голові, присутній слабкість, підвищується температура, збільшуються підщелепні лімфовузли);
- ураження органів дихання (закладеність носа, нежить, біль у горлі, кашель сухий або з виділенням мокроти);
- ураження слизових (біль і почервоніння в області очей, сльозовиділення, кон’юнктивіт).
Перші ознаки ГРВІ у дитини часто характеризуються раптовим початком з чітко позначеним «общеинфекционным» синдромом. При парагрипі або аденовирусе перші ознаки ураження органів дихання (горла, носоглотки), а також почервоніння і свербіж кон’юнктиви ока.
Звичайно, було б простіше і батькам і лікарям, якщо б протягом ГРВІ у дітей завжди було класичним. Однак дитячий організм являє собою дуже складну систему, і його реакцію на проникнення того чи іншого вірусу не можна передбачити на всі сто відсотків.
Так як вгадати і спрогнозувати перебіг хвороби батькам навряд чи вдасться, необхідно знати про стани, при яких доведеться звернутися до лікаря самим нагальним чином.
Симптоми ГРВІ у дітей, що вимагають термінового звернення до лікаря:
- Показники температури перевищили 38°C і мало або взагалі не реагують на прийом жарознижуючих препаратів.
- У дитини порушується свідомість, він розгублений, байдужий, може впасти в непритомність.
- Дитина скаржиться на сильний головний біль, а також неможливість повернути шиєю або зробити нахил вперед.
- На шкірі з’являються судинні зірочки, висипання.
- З’являється біль в грудях, дитина починає задихатися, йому важко дихати.
- З’являється різнобарвна харкотиння (зелена, коричнева або рожева).
- З’являються набряки на тілі.
- З’являються судоми.

Не варто займатися самолікуванням, особливо, якщо справа стосується вашої дитини. Звертайте увагу також на інші органи і системи малюка, щоб не пропустити починається запалення.
Діти досить чутливі до підвищення температури тіла: надмірно висока температура сприяє появі судом у дитини. З-за цього не слід допускати підвищення температури більше 38-38,5°C.
Температуру до 38°С збивати не варто, так як не потрібно заважати організму виконувати свою роботу – боротися з проникненням вірусу. Це може спровокувати появу ускладнень. Що необхідно робити:
- не панікувати;
- спостерігати за станом дитини – зазвичай через 3-4 дні температура повинна стабілізуватися.
Затяжне ГРВІ у дитини з неснижающейся температурою може свідчити про приєднання бактеріальної інфекції. Трапляється і таке, коли показники температури після вірусної інфекції знизилися, малюк начебто пішов на поправку, проте через кілька діб йому знову стало гірше, з’явилася лихоманка. У такій ситуації зволікати з викликом лікаря не варто.
При класичному перебігу ГРВІ температура може триматися не більше 2-3-х діб, максимально – п’ять днів. За цей час організм повинен побороти вірус, виробивши власні антитіла до нього. Важливо: не слід спеціально збивати температуру до норми, можна лише знизити її, щоб організм продовжував боротися з інфекцією.
Кашель при ГРВІ у дітей – досить частий симптом. Зазвичай він присутній на тлі підвищення температури, нежитю та інших ознак захворювання. З початком хвороби спостерігається сухий кашель (без виділення мокроти).
Як правило, кашель при вірусних інфекціях триває 15-20 днів, однак якщо його тривалість перевищує три тижні, то можна запідозрити хронічний кашель. В таких випадках просто необхідна грамотна консультація дитячого пульмонолога і алерголога, а також призначення комплексної терапії.
Блювота у дитини при ГРВІ може виникнути одночасно з появою високої температури і кашлю. Насилу відходить мокрота, густа і в’язка, виявляє роздратування на органи дихання і провокує у дитини напади болісного кашлю.

Блювотний рефлекс спрацьовує в результаті переходу возбудительного сигналу з центрів кашлю на блювотні центри. У деяких випадках блювота може з’явитися внаслідок накопичення великої кількості слизових виділень в порожнині носоглотки, але в такому випадку з’являється блювота і без кашлю. Найчастіше блювання на фоні кашлю не буває щедрою, видимого полегшення малюкові не приносить.
Лікування фіброзу легенів народними засобами
У більшості випадків при ізольованому перебігу це захворювання не викликає ніяких ускладнень. Однак, якщо хвороба буде протікати сочетано, то можуть розвинутися різні, досить небезпечні ускладнення.
Якщо почати лікувати трахеїт вчасно, то з ним можна буде впоратися всього за пару тижнів.
Антибіотики, як правило, не призначаються з перших днів захворювання. Вірусна етіологія ГРВІ передбачає застосування в першу чергу противірусних препаратів (римантадин, занамівір).
Антибіотикотерапія у дорослих використовується при виявленні таких ознак:
- тривалі (більше трьох днів) високі показники температури тіла;
- симптоми загальної інтоксикації організму (головний біль, запаморочення, нудота, ціаноз);
- хрипи, утруднення дихання, неможливість откашлять вміст бронхів, тяжкість за грудиною;
- підвищена швидкість осідання еритроцитів (ШОЕ);
- підвищена кількість лейкоцитів в крові;
- поява видимих вогнищ мікробного ураження (флегмони, абсцеси, фурункули, гнійний синусит);
- відсутність позитивної динаміки розвитку захворювання (незважаючи на лікування, патологічна симптоматика прогресує);
- літній вік і ослаблена імунна система організму.
Призначають антибіотики при ГРВІ у дорослих також при змішаній і ускладненій формі захворювання.
Настоянка прополісу
Зовсім не важливо, пов’язана астма з алергією чи ні — в основі нападів лежить один і той самий фізіологічний механізм: при наявності того чи іншого зазвичай нешкідливого елемента (пилок, холод, стрес та ін
у астматика починається сухий кашель, а дихання поступово все більше і більше ускладнюється. Запалені бронхи заважають дихати, а спазми бронхіальних м’язів можуть навіть повністю зупинити дихання. Поряд з таким станом відбувається надлишкове виділення слизу, що перешкоджає попаданню повітря в легені. Саме цим і пояснюється характерне свистяче дихання у астматиків.
Під час нападу дихати стає дуже важко, неможливо залишатися в лежачому положенні, посилюється потовиділення, починається прискорене серцебиття, хворого охоплює сильна тривога. У перерві між нападами здається, що все прийшло в норму», тільки бронхи як і раніше залишаються дуже чутливими і дихати все-таки важко — дихання трохи гучне і свистяче, в будь-який момент може початися напад сухого кашлю, і астматика переслідує відчуття стискання в грудній клітці.
Чотири ознаки астми:
- утруднене дихання поступово стає важко дихати;
- починаються приступи ядухи;
- кашель;
- дихання стає шумним і свистячим.
Базовий компонент сумішей при ароматерапії бронхіальної астми: естрагон.
Для зовнішнього застосування нанесіть 2 краплі на область сонячного сплетення і на горло і помасажуйте.
Для зовнішнього застосування попросіть фармацевта приготувати у флаконі 10 мл наступне масажне масло:
- Ефірної олії естрагону 1 мл
- Ефірного масла ромашки благородної 1 мл
- Ефірної олії пижма однорічній 1 мл
- Ефірної олії аммі зубної або виснаги 1 мл
- Рослинного масла лавра олександрійського 6 мл

Нанесіть 5 крапель на область сонячного сплетення, верхню частину спини і вздовж хребта. Повторюйте кожні 15 хвилин аж до помітного поліпшення.
Для прийому всередину приймайте 2 капсули масла естрагону з дозуванням 50 мг 3-4 рази в день.
Для прийому всередину попросіть фармацевта приготувати наступні желатинові капсули:
- Ефірної олії любистка 30 мг
- Ефірного масла лимона 30 мг
Приймайте по 1 капсулі зранку і ввечері для зміцнення і захисту печінки 10 днів протягом кожного місяця.
- Уникайте всього того, що викликає напади астми:
- Алергени: пилові кліщі, пил, пилок, тварини (кішки, собаки, коні, птахи, деякі продукти харчування та ін).
- Атмосферне забруднення (проживання у великому місті, автомобільні вихлопи) і забруднене повітря на роботі (магазин будівельних матеріалів або парфумерних товарів) або вдома (запахи пічної сажі, фарби, одягу після хімчистки, оздоблювальних матеріалів та ін).
- Активне або пасивне куріння.
- Деякі медикаментозні препарати: аспірин, протизапальні засоби.
- Особливості кліматичних умов: туман і холод.
- Інфекційні захворювання органів дихання (нежить, бронхіт, грип та ін). Від усіх хвороб не вбережешся, зате завжди їх можна своєчасно лікувати так, як це дійсно необхідно! Рецидивуючі бронхіти часто приховують астму.
- Надмірне фізичне навантаження, особливо на холоді.
- Сильні емоції: гнів або стрес. Напад астми також може бути результатом нестримного сміху або. оргазму, але, мабуть, рекомендацій від стриманості не піде.
- Якщо вас турбує гастроезофагеальний рефлюкс, то його необхідно лікувати.
Будьте обережні:
- Менструальний цикл: напади астми можуть посилюватися або частішати перед початком менструації.
- Алергія і харчова непереносимість можуть проявлятися у вигляді нападів астми. Втім, напади астми іноді є наслідком вживання деяких продуктів харчування.
- Алергія і харчова непереносимість можуть з’явитися відразу після того, як, наприклад, яйця, риба, морепродукти, горіхи, арахіс потраплять в шлунок.
- Алергія і харчова непереносимість можуть виникнути через деякий час після вживання молока, шоколаду, пшениці, цитрусових, різних добавок в їжу (харчові барвники, консерванти, сульфіти і т. д.), соя, лимон, кукурудза.
- Слідкуйте за реакціями вашого організму після їжі. Якщо немає приводів для занепокоєння, то тим краще для вас!
- Аспірин: може викликати у деяких людей напад астми. Виною тому — саліцилати, що входять до його складу.
- Саліцилати присутні і в багатьох інших продуктах — вони здатні викликати кропивницю, риніти і, зрозуміло, напади астми. Також необхідно перевірити всі продукти, які контактують з порожниною рота: зубну пасту, ополіскувачі, антисептичні пастилки та ін. Дане застереження має значення, якщо ви сприйнятливі до саліцилатів — в іншому випадку воно вас не стосується!
- У вашому будинку або квартирі не повинно бути пилу, пуху, вовни, розкиданої всюди одягу.
- Уникайте того, щоб в житлових кімнатах було дуже жарко. Температура в квартирі або в робочому кабінеті не повинна перевищувати 18 °C.
- Молочні продукти підсилюють алергічні реакції.
Ателектази легенів
Класифікація
В основу класифікації можуть бути покладені причини, що викликають захворювання дихальних шляхів у дитячому віці. Серед них виділяються:
- Інфекції (віруси, мікроби, грибки).
- Алергії та імунологічна недостатність.
- Аспірація.
- Сторонні тіла дихальних шляхів.
- Вади розвитку.

По локалізації патологічного процесу розрізняють:
- Хвороби верхніх дихальних шляхів (риніт, фарингіт, ларингіт, ангіна, тонзиліт);
- Хвороби нижніх дихальних шляхів (трахеїт, бронхіт, пневмонія, плеврит).
Гортань займає проміжне становище, тому деякі відносять ларингіт до захворювань нижніх дихальних шляхів.
Наприклад, почавшись з риніту, захворювання при несприятливих умовах переходить на бронхіт або пневмонію. Істотну роль при цьому відіграють умови проживання, екологія, характер харчування дитини, гіповітаміноз і вище перераховані особливості будови системи дихання.
Діагностика респіраторних інфекцій
Для постановки діагнозу використовуються загальні методи діагностики, починаючи з розпитування батьків та дитини про симптоми і початку захворювання. Огляд дозволяє виявити ціаноз носогубного трикутника, наявність виділень з носа, ступінь участі дихальної мускулатури в акті дихання, утруднене вдиху або видиху.
Огляд порожнини носа проводиться із застосуванням риноскопа. Перкусія (простукування) та аускультація (прослуховування) легень дає уявлення про стан бронхів та легеневої тканини. Рентгенологічний метод дослідження є одним з найбільш інформативних.
Діагностику інфекцій верхніх дихальних шляхів встановлює на підставі клінічної картини і результатів лабораторних обстежень. Клінічна картина різних форм захворювань верхніх дихальних шляхів має багато спільного і необхідно завжди диференціювати одну нозологію від іншої. Діагноз встановлює лікар-педіатр, лікар-отоларинголог.
Хвороби верхніх дихальних шляхів – група захворювань запальної і незапального природи. До них відносяться банальний нежить і ангіна, хвороби гортані і трахеї, приносових пазух.
Патологією верхніх дихальних шляхів інфекційної етіології страждає кожна четверта людина на Землі. Клімат Росії призводить до масових спалахів цих захворювань в період з вересня по квітень.
В даний час медициною вивчено до 300 мікроорганізмів, здатних викликати хвороби верхніх дихальних шляхів. Крім того, робота на шкідливих виробництвах і постійне вдихання дратівливих хімічних речовин може викликати хронічні запалення носа, глотки і гортані.
Постановка діагнозу при хворобах верхніх дихальних шляхів починається з огляду пацієнта. Лікар звертає увагу на почервоніння шкіри під носом, утруднення дихання, епізоди чхання, кашлю, сльозотечі. Оглядаючи глотку, лікар може побачити виражені почервоніння і набряки слизових оболонок.
Для визначення типу збудника, що спричинив розвиток хвороби, застосовують бактеріологічні тести, беруть мазки із зіву і носа. Для визначення вираженості запального процесу і відповіді імунної системи на нього для досліджують загальні аналізи крові та сечі.
Діагноз ставиться на основі збору анамнезу та інструментальних методів дослідження. Спочатку лікар вислуховує скарги пацієнта, виявляє супутні хвороби, з’ясовує умови життя хворого. Після додаткової аускультації лікар вже може виставити первинний діагноз, але для уточнення проводить кілька додаткових досліджень.
Хворому можуть бути призначені рентгенографія легенів, здача мокротиння на баканализы і спірометрія.
Загальний аналіз крові завершує діагностування запалення трахеї.
Зігріваючі компреси
- Змішують 1 частину 40%-ної горілки і 2 частини води. Отриманий розчин підігрівають до температури тіла, просочують їм марлеву серветку і, розправивши її, кладуть на шийну область. Поверх кладуть вощений папір, потім вату (товстим шаром), зміцнюють за допомогою бинта або зав’язують шматком тканини (можна шарфом) і залишають на 5-6 год. На самому початку фіброзу легенів цю процедуру повторюють вранці і ввечері. Коли гострий період пройде, роблять компрес тільки ввечері і залишають на ніч.
- Змішують по 1 столовій ложці борошно, гірчичний порошок, мед, горілку, сік алое, нутряний жир (можна замінити нерафінованою соняшниковою олією) і підігрівають на водяній бані. На спину хворого кладуть марлю, просочену отриманою сумішшю. Зверху кладуть ще один шар марлі, потім поліетиленову плівку, а зверху теплу вовняну хустку. Компрес бажано зафіксувати і залишити на ніч. Для лікування, як правило, буває достатньо 2 процедур.
- 2 частини меду, 1 частина соку алое і 3 частини горілки підігрівають до 40°С, добре перемішують і використовують у вигляді компресу на верхню частину грудей при фіброзі легень.
Хвороби нижніх дихальних шляхів
До цієї категорії відноситься трахеїт, бронхіт і пневмонія. Багато батьків починають самостійно лікувати захворювання, і тим самим лише погіршують ситуацію. Народними засобами в цьому випадку не обійтися, а препарати повинен призначати лікар.
Трахеїт
Запалення трахеї, як правило, виникає після попередніх запалень верхніх дихальних шляхів. Втім, може бути ізольоване первинне ураження трахеї.
Причини поділяються на:
- Інфекційні (віруси, пневмококи, збудники кору та кашлюку).
- Неінфекційні (гаряче або холодне повітря, пасивне куріння та вдихання алергенів або парів хімікатів).
Основна скарга – низький грубий кашель на тлі болю і печіння за грудиною. Відділення мокротиння нехарактерно, якщо вона є, то вона убога і в’язка. Кашель носить нападоподібний характер, провокується лежачим положенням, хвилюванням, сміхом чи плачем. Частота нападів знижується через 4-5 днів.
Підхід до лікування аналогічний захворювань верхніх дихальних шляхів – питво, зволоження повітря, жарознижуючі при високій температурі. При появі гнійного мокротиння в поєднанні з високою температурою показані антибіотики, які можна вводити за допомогою небулайзера. Лікар призначить протикашльові препарати, засоби для розрідження мокротиння, полівітаміни.
Бронхіт
Встановлено, що понад 99% бронхітів мають вірусну етіологію. Передача його від хворого до здорової дитини здійснюється повітряно-крапельним шляхом через ніс або рот. Переохолодження організму не грає ролі в розвитку хвороби.
Найчастіше ці хвороби органів дихання у дітей викликаються вірусом грипу, улюбленим місцем проживання якого є саме слизова бронхів, в той час як верхні відділи дихальних шляхів уражаються іншими видами вірусів.
Варто зауважити, що бактеріальні, мікробні бронхіти протікають значно важче вірусних. Потрапивши в систему розгалуженого бронхіального дерева, інфекційний агент (а можливо і алерген) викликає запалення слизової оболонки, яке проявляється набряком і підвищеним утворенням слизу.
Вільний простір порожнистої трубочки під назвою бронх значно зменшується. Для того щоб полегшити видалення слизу в бронхах властиво скорочуватися, спазмовані, що ще більше звужує просвіт.
Причому у дітей ця здатність бронха до скорочення виражена значніше, чим у дорослих. До набряку слизової, підвищеному утворенню слизу всередині бронха приєднується бронхоспазм – ось таким чином відбувається бронхіт.
Дитячі бронхіти протікають важче дорослих. Це пояснюється тим, що мокрота з рідкого стану швидко переходить в в’язке й густе. Ефективно очистити бронх від такої слизу, що проникла глибоко в самі вузькі ділянки бронхіального дерева, дитина може тільки при інтенсивному кашлі, а для нього це важко із-за слабкого розвитку дихальної мускулатури. Особливо важко продуктивний, що очищає бронхи, кашель виникає у дітей дошкільного віку.
Чим небезпечний бронхіт:
- Порушенням постачання киснем всіх органів, тканин і клітин.
- Скупчення і розмноження вірусів у судженого бронху може перейти на тканину легені з розвитком пневмонії.
Як бронхіт проявляється у дитини? На фоні підвищеної температури і погіршення загального самопочуття, вираженого млявістю, стомлюваністю, зниженням апетиту, сонливістю з’являється кашель і утруднене дихання.
Якщо винуватець хвороби не вірус, а бактерія, стан ще більше ускладнюється:
- Температура висока (сильний жар).
- Дихання часте неглибоко.
- Є ознаки інтоксикації у вигляді нудоти, блювання, головного болю.
- Закладеності носа і утрудненого носового дихання немає.
Як допомогти дитині? Важливо запам’ятати наступне:
- Даючи дитині підвищену кількість рідини, ви підтримуєте кров у більш рідкому стані, тим самим перешкоджаєте згущення харкотиння, не даєте їй засохнути і пристане до стінок бронхів.
- Вологе прохолодне, добре провітрюване приміщення вкрай необхідно для малюка в період хвороби.
- Боротьбу з температурою жарознижувальними засобами починайте після досягнення позначки на термометрі понад 38 градусів.
- Гуляйте з дитиною після завершення гострої фази хвороби для поліпшення вентиляції легень і зниження вірусної активності.
- Допоможіть видалити мокротиння з бронхів спеціальним масажем.
Суть масажу полягає в забезпеченні дренажного положення тіла малюка, тобто, досить покласти його до себе на коліна обличчям вниз і положенням голови нижче попи. Постукуючи загребающими рухами зігнутих пальців між лопатками по напрямку від попереку до голови, ви допомагаєте мокротинні переміститися в більш широкі відділи бронхів. Потім різко посадіть дитину до себе на коліна і просіть покашляти. Повторіть 2-3 рази.
Коли не можна робити масаж? У двох випадках: при гострій фазі хвороби і високій температурі, і якщо малюк ще не вміє покашляти при проханні.
Є ще 4 «табу», які, на жаль, порушують багато батьків, збільшуючи вираженість дихальних розладів у дитини, хворого бронхітом. Категорично заборонено:
- Робити інгаляції, особливо гарячі, тому що це збільшить кількість мокротиння. Не вміючи відкашлювати, дитина може захлинутися.
- Купати дитину у ванні з тієї ж причини (тепла вода випаровується, створюючи ефект інгаляції).
- Давати відхаркувальні і розріджують мокротиння засоби з причини їх дії в зоні верхніх дихальних шляхів.
- Кутати, розтирати зігріваючими мазями, ставити гірчичники, так як це призведе до підвищення температури.
Одного разу перенесений бронхіт не гарантує повторного захворювання, тому профілактичні заходи вельми доречні.
Пневмонія
Запалення легеневої тканини, що супроводжується інтоксикацією, кашлем і дихальною недостатністю називається пневмонією. Характерний ріст захворюваності в період підйому ГРВІ. Хвороби схильні діти будь-якого віку, починаючи з періоду новонародженості.
Незважаючи на успіхи медицини, смертність від пневмонії змушує шукати нові шляхи лікування. Поставити діагноз нескладно, керуючись даними аускультації, аналізу крові і рентгенограми.
Причини пневмонії різноманітні і залежать від віку. У новонароджених це найчастіше вірус герпесу, хламідії, вітряна віспа та цитомегаловірус. На першому році життя – пневмокок; у дошкільнят – кишкова паличка, протей, стафілокок;
у школярів – мікоплазма і хламідія. Причина внутрішньолікарняної пневмонії – стрептокок, стафілокок, кишкова паличка, клебсиелла. Допомогти встановленню причини може посів виділень з носа і зіву, посів харкотиння, ІФА і ПЛР.
Розрізняють внутрибольничную і домашню пневмонію. Початок хвороби в перші 3 доби після надходження в стаціонар або перші 3 доби після виписування дає підставу вважати таку пневмонію внутрішньолікарняної.
По рентгенограмі можна уточнити ступінь ураження:
- Вогнищева.
- Сегментарна.
- Крупозна.
- Інтерстиціальна.
Ускладнені форми зустрічаються у вигляді плевропневмонії, набряку легкого, абсцесу, фіброзу, дихальної недостатності, пневмоторакс, поліорганна недостатність, сепсис.
Клінічна картина пов’язана зі ступенем ураження – чим більшою мірою залучена в запальний процес легенева тканина, тим важче симптоми хвороби. При осередкової пневмонії на тлі підвищення температури в межах 38 градусів присутні загальні симптоми інтоксикації, кашель, задишка.
В акті дихання бере участь міжреберна мускулатура. У міру поширеності процесу наростають ознаки дихальної недостатності – болі у грудній клітці, озноб, кашель стає болісним, мокрота убога, іноді рожевого кольору.
Основа лікування – антибактеріальна терапія антибіотиками різних груп, причому дотримується правило зміни антибіотика у разі його неефективності протягом 48 годин. Додатково застосовують бронхолітики, муколітики, жарознижуючі та антигістамінні засоби. В період одужання рекомендується масаж, фізіолікування, ЛФК.
Своєчасна адекватна терапія дає високі шанси на одужання. Сумно закінчуються випадки з высоковарулентной флорою, стійкої до антибіотиків, у дітей із соматичною патологією та гнійно-септичними ускладненнями, имунодефицитами.
Базовий компонент ароматерапії: базилік або естрагон
Астма на нервовому грунті так чи інакше пов’язана з душевним дискомфортом або негативними емоціями по відношенню до чого-небудь або до кого-небудь з нашого повсякденного оточення. Так, наприклад, письменник Марсель Пруст страждав від астми психосоматичного характеру всю свою життя і в кінцевому рахунку від неї помер.
Як і при алергічній астмі, ефірні олії під час нападів слід застосовувати зовнішньо — не вдихайте їх, якщо у вас вже почався приступ! Вони не замінять інгалятор, використовуваний вами для полегшення дихання;
Мета лікування ефірними маслами полягає в зменшенні частоти та інтенсивності нападів астми — це цілком досяжне завдання.
Базовий компонент при ароматерапії астми: масло ромашки римської.
Для зовнішнього застосування нанести 1 краплю на область сонячного сплетення і 1 краплю капніть під язик. Повторюйте процедуру через кожні 15 хвилин під час нападу.
Попросите приготувати в аптеці наступне масажне масло:
- Ефірної олії лаванди вузьколистої 1 мл
- Ефірної олії гісопу лікарського стелиться 1 мл
- Ефірного масла мирта звичайного 1 мл
- Ефірного масла мандарина 1 мл
- Рослинного масла лавра олександрійського 30 мл
Масажуйте спину, грудну клітку, хребет 2-3 рази в день в якості профілактики та кожні 30 хвилин під час нападів аж до помітного поліпшення.
Якщо ви віддаєте перевагу капсули для прийому всередину, попросіть фармацевта приготувати наступні желатинові капсули:
- Ефірного масла ромашки 10 мг
- Ефірної олії лаванди вузьколистої 10 мг
- Ефірної олії майорану 30 мг
- Ефірного масла сосни звичайної 20 мг
- Ефірної олії аммі зубної або виснаги 10 мг
Для профілактики: 2 капсули в день протягом 10 днів, терапію проводити раз на місяць.
При нападах: 2 капсули 3 рази в день протягом 3-4 днів.
- Регулярно займайтеся спортом: спорт допомагає відновити правильне дихання і зробити напади більш рідкісними. Особливо рекомендується плавання — як і всі щадні види спорту. Уникайте фізичних навантажень на холодному повітрі (наприклад, біг взимку) — вони можуть спровокувати напад. Категорично забороняється займатися дайвінгом.
- Негайно лікуйте всі інфекційні захворювання органів дихання (з допомогою ефірних масел це дуже легко!) — вони провокують напади астми.
- Не паліть і уникайте накурених приміщень.
- Навчіться розслаблятися. Регулярна релаксація і особливо йога (поліпшення дихання) напевно підуть вам на користь.
- Астму необхідно обов’язково контролювати — в іншому випадку це загрожує серйозними наслідками для здоров’я на довгі роки вперед. Можна вважати, що ситуація виходить з-під контролю, якщо напади у в ас бувають кожен день і кожну ніч, якщо ви постійно користуєтеся інгалятором, якщо у вас помітно утруднюється дихання навіть при помірному фізичному навантаженні (через кожні 3 з тупеньки сходи у вас з’являється задишка).
- Якщо ви живете в несприятливих екологічних умовах (наприклад, у великому місті), то приймайте 2 таблетки вітаміну С щодня (як мінімум 1 м).
Для масажу:
- Змастіть хворобливу область живота 2 краплями ефірного масла базиліка або естрагону і повільно масажуйте.
Для прийому всередину при лікуванні цього шлунково-кишкового захворювання:
- Капніть 1 краплю на шматочок цукру або чайну ложку рослинної олії і тримати у роті до повного розсмоктування. Застосовуйте 3 рази в день.
Для масажу у флаконі (10 мл) змішайте:
- Ефірне масло естрагону 2 мл
- Ефірне масло коріандру 1 мл
- Ефірне масло лавандіна супер 1 мл
- Ефірна олія м’яти перцевої 1 мл
- Ефірне масло майорану 2 мл
- Олії звіробою продірявленого 3 мл
Візьміть 6-10 крапель суміші і змащуйте нею область живота і нижньої частини спини 4 рази на день протягом 5-7 днів.
Для лікування даного захворювання ШКТ попросіть фармацевта виготовити желатинові капсули наступного складу:
- Ефірного масла базиліка запашного 10 мг
- Ефірної олії м’яти перцевої 15 мг
- Ефірної олії фенхеля запашного 35 мг
- Ефірної олії лаванди колоскової 10 мг
Приймайте по 1 капсулі вранці, вдень і ввечері протягом 5-7 днів.
- У хворих часто відзначається зниження апетиту, посилене недостатнім засвоєнням вітамінів і мінералів, що призводить до нестачі поживних речовин, зокрема вітаміну А, провітаміну А, віт амінів групи В (особливо B9, B12), D, E, кальцію, заліза, магнію, селену і цинку). У зв’язку з цим у період лікування рекомендується прийом мультивітамінних і мінеральних комплексів.
- Зменшення больових відчуттів сприяє прийом пробіотиків, глютамина і амінокислот Омега-3. Маючи протизапальну дію, вони сприяють відновленню цілісності слизової оболонки кишечника й поліпшенню загального стану. Рекомендуються в якості додаткової терапії дорослим і дітям.
- На жаль, рекомендації дотримуватися режиму харчування (обмежити споживання харчових волокон рослинного походження, збільшити споживання молочних продуктів тощо) н е сприяють поліпшенню самопочуття.
- Збільште до 3-4 разів на тиждень споживання свіжих овочів і фруктів, цільних круп (наприклад, рису), жирних сортів риби (лосося, сьомги, оселедця, скумбрії).
- Уникайте продуктів, здатних погіршити ваше самопочуття: кукурудзи, пшениці, молока, дріжджів, яєць, картоплі, житнього борошна, вівсянки, чаю, кави, яблук, шоколаду та грибів.
- Заключний розділ статті присвячений тому, як лікувати таке порушення ШКТ, як синдром роздратованого кишечника.
Лікування проблеми з ШКТ аэрофагии
Вас турбують гази і здуття живота, відчуття переповненого шлунка; у вас відрижка і/ або ви регулярно розслабляєте ваш пояс в кінці або під час їжі? Тоді у вас аерофагія. Скупчення газів, які прагнуть вийти назовні у вигляді відрижки, утворюються у вашому шлунку.
Ті, які трансформуються в метеоризм, обумовлені бактеріями кишечнику. У більшості випадків винні в цьому вуглеводи (бобові, капуста та інші продукти), що викликають бродіння. Дуже часто це буває пов’язано з харчовою непереносимістю — якщо вживається невелика кількість таких продуктів, то це не призводить до негативних наслідків, але, якщо ви переїли.
Наприклад, це характерно для макаронних виробів або хліба з-за наявною в них клейковини, або для продуктів на основі молока. Стрес і куріння також є факторами, що приводять до аэрофагии, так як вони заважають перетравлювати їжу належним чином.
Можна мимоволі заковтувати повітря під час дзвінка або коли ви жуєте жувальну гумку — рано чи пізно він все одно вийде назовні. Буває і так, що шлунковий сік уповільнює перетравлення їжі; у літніх людей знижена кислотність шлунка зустрічається досить часто.
Базовий компонент ароматерапевтичного лікування цього шлунково-кишкового захворювання: естрагон.
Для прийому всередину:
- Капніть 1 краплю на нейтральну таблетку (або, як варіант, на шматочок цукру) і тримати у роті до повного розсмоктування. Повторюйте процедуру 1-3 р аза в день протягом 3-4 днів.
Для масажу змішайте:
- Ефірне масло естрагону 1 краплю
- Ефірне масло зіри (куміна) 1 краплю
- Ефірна олія м’яти перцевої 1 краплю
- РМ звіробою 2 краплі
Повільно масажуйте живіт і область шлунка після основних прийомів їжі протягом 1 тижня.
Для лікування цієї хвороби ШКТ у дорослої людини змішайте:
- Ефірне масло коричника китайського 1 краплю
- Ефірне масло базиліка 1 краплю
- Ефірна олія м’яти перцевої 1 краплю
Нанесіть 3 краплі на маленький шматочок хлібного м’якушки — перед кожним прийомом їжі.
- Добре проваривайте всі зернові продукти, макаронні вироби, пироги, хліб, млинці та ін)
- Не заглатывайте повітря, коли ви їсте, чи п’єте занадто гарячу їжу або напої (суп або чай). І ні в якому разі не жуйте жувальну гумку протягом всього дня. Так ви не тільки заковтує повітря, але і марно провокуєте посилене виділення шлункового соку, адже в цей момент їжа не надходить до вас в шлунок.
- Уникайте вживання продуктів, які погано перетравлюються — уповільнення травних процесів призводить до бродіння (сушені овочі — особливо якщо вони не піддалися достатній термічній обробці, а також жирні страви тощо).
- Коли ви варите сушені овочі або цільнозернові продукти, додайте трохи водоростей (комбу) у воду. Це поліпшить перетравлення їжі при подальшому вживанні!
- Виливайте воду, в якій ви в арили або промивали так звані «небезпечні» продукти.
- Не зловживайте сирими і сушеними овочами (особливо квасолею), капустою, цибулею, каштанами, бананами.
- Добре прожевывайте їжу, перш чим її проковтнути.
- Не упрямьтесь: якщо у вас погано засвоюються ті і інші продукти, то навряд чи це зміниться.
- Уникайте вживання тих продуктів, які погано засвоюються усіма: індустріальна їжа, перенасичена жирами і консервантами, а також продукти, що містять штучні замінники цукру.
- Їжте в спокійній обстановці, ніколи не поспішайте; не приймайте їжу в стресовому стані і на ходу.
Далі ви дізнаєтеся, як лікувати таке порушення роботи шлунково-кишкового тракту, як метеоризм.
Як правильно лікувати хвороби органів дихання у дітей?
Це одна з найбільш поширених і разом з тим найбільш неприємних шлунково-кишкових проблем. Здуття живота відбувається через накопичення великої кількості газів в кишечнику, що супроводжується збільшенням живота в об’ємі і неприємним відчуттям розпирання зсередини. Зменшити утворення газів можна за допомогою ефірних масел.
Базовий компонент ароматерапевтичного лікування цієї хвороби шлунково-кишкового тракту: естрагон або базилік.
- Капніть 1 краплю під язик (або на шматочок цукру, на нейтральну таблетку, в чайну ложку оливкової олії, яку необхідно тримати у роті до повного розсмоктування) і нанесіть 2 краплі на живіт перед масажем.
При лікуванні цієї проблеми з ШКТ дуже корисний масаж.
Змішайте:
- Ефірне масло естрагону (або базиліка) 1 краплю
- Ефірна олія кмину 1 краплю
- Ефірне масло коріандру 1 краплю
- Ефірна олія м’яти перцевої 1 краплю
- РМ лавра олександрійського 1/2 чайної ложки
Масажуйте живіт і шлунок через кожні 2-3 години аж до помітного поліпшення.
Замовте в аптеці наступне засіб для лікування цього захворювання шлунково-кишкового тракту:
- Ефірного масла базиліка запашного 10 мг
- Ефірної олії м’яти перцевої 10 мг
- Ефірної олії зіри 10 мг
- Ефірної олії фенхеля або солодкого кропу 10 мг
- Есенції лимона 10 мг
Приймайте по 1 капсулі після кожного прийому їжі протягом 20 днів.
- У вас здувся живіт в самий невідповідний момент? Капсули з вугіллям чи глиною є справжніми «губками» для газів. Вам відразу ж стане легше. Але не рекомендується вживати їх протягом тривалого часу, так як глина і вугілля володіють такими потужними властивостями, що діють подібно справжнім «насосів»: вони притягують до себе все, включаючи корисні речовини (медичні препарати, вітаміни тощо). Пийте їх в перервах між прийомами їжі.
- При приготуванні страв користуйтеся спеціями і приправами, що усувають здуття кишечника. Такими властивостями володіють імбир і перцева м’ята.
- Додавайте в їжу ефіроолійні рослини (петрушка, кріп, коріандр, базилік, кмин та ін) — вони відмінно допомагають травленню, перешкоджають надмірному утворенню газів і надають стравам відмінний смак.
- Не пийте занадто багато під час їжі, навіть коли мова йде про воду — особливо газовану воду або напої з вмістом цукру. Більшість виробників напоїв використовують інгібітори: добавки (сидр, пиво, сиропи, солодка газована вода); таніни (вино, кава, чай); алкоголь (всі алкогольні напої); жири (молоко і какао); рафінований цукор (всі наявні в продажу напої з вмістом цукру). Дуже погано засвоюються організмом молочні коктейлі.
- Капуста, суха квасоля, ріпа і цибулю сприяють утворенню газів у людей, схильних до метеоризму — намагайтеся не їсти їх занадто багато.
- Відмовтеся від молочних продуктів або, принаймні, зменшити їх споживання — лактоза перетравлюється дуже погано.
- Обмежуйте себе в продуктах, багатих харчовими волокнами, але не відмовляйтеся від них повністю. Слід поступово збільшувати вміст харчових волокон у вашому раціоні і встановити вашу особисту норму.
- З усіх жирів оливкова олія корисніша всього.
- Намагайтеся не вживати дріжджові продукти, що викликають бродіння: хліб, випічка, сири, сметана.
Наступний розділ статті присвячений тому, чим лікувати кишковий розлад діарею.
Не варто розповідати, що таке запор. На жаль, пов’язані з ним проблеми всім нам добре відомі. Тим не менш… Ви впевнені, що у вас саме запор? Відповідь на це питання аж ніяк не очевидний — багато людей вважають, що страждають запорами тільки тому, що випорожнюються не кожен день.
І якщо при лікуванні цього захворювання кишкового-тракту ароматерапія здатна надати дієву допомогу, це не означає, що слід забути про правила гігієни харчування і активний спосіб життя! Більшість запорів викликані незбалансованим харчуванням (зокрема, відсутністю волокон і недостатньою кількістю рідини), лінню (а як інакше назвати пасивний спосіб життя?
Для масажу:
- Капніть 2 краплі ефірного масла імбиру на живіт і інтенсивно масажуйте широкими масажними рухами (як при масажі кишечника).
Для прийому всередину:
- Перед їжею капніть 1 краплю в кавову ложечку оливкової олії і дер жите у роті до повного розсмоктування.
Для ефективного лікування цієї хвороби ШКТ можна приготувати суміш наступного складу:
- Ефірне масло імбиру 1 краплю
- Ефірне масло базиліка 1 краплю
- Ефірне масло майорану 1 краплю
- Ефірне масло живиці 1 краплю
- Масла калофиллума 12 кавової ложечки
Масажними рухами втирайте в область живота (в тому числі і в о бласть кишечника) 3 рази в день протягом 1 тижня.
У 12 кавової ложечки оливкової олії капніть:
- Ефірне масло естрагону 1 краплю
- Ефірне масло базиліка 1 краплю
- Ефірне масло сосни приморської зірчастої 1 краплю
- Ефірне масло імбиру 1 краплю
При лікуванні цього шлункового розладу масажними рухами втирайте в область живота (в то му числі і в нижню його частину) 1-2 рази в день протягом тижня.
- Увага! Запор не тільки викликає певний дискомфорт, але здатний спровокувати деякі кишкові захворювання. Більш того, хронічний запор викликає рак ободової кишки. Тому поставтеся до лікування запору з усією серйозністю!
- Нерідко причиною запорів стають дієти, спрямовані на зниження ваги: отримуючи обмежену кількість їжі і страждаючи від цього, організм автоматично знижує обсяг її виходу.
- Перше, з чого потрібно почати лікування запору, це збільшити кількість з’їдених овочів і фруктів, цільних злаків (кукурудзи, рису, проса, гречки і т. д.), бобових (сочевиці, сухого гороху, квасолі та ін), горіхів (мигдалю, ліщини), пити більше рідини і активніше рухатися. Налягайте на чорнослив, інжир, родзинки — вони багаті клітковиною, недостатність або відсутність якої викликає порушення перистальтики кишечника.
- Уникайте продуктів, що містять висівки, харчові волокна якого подразнюють кишечник і перешкоджають засвоєнню мінеральних речовин.
- Стрес (в будь-яких його проявах) посилює проблему. Намагайтеся уникати стресів, а якщо не вдається, то просто розслабтеся — е то набагато ефективніше, чим прийом проносних!
- Кілька хвилин ранкової гімнастики і 1 стакан води перед сніданком гарантовано покращують перистальтику кишечника.
- Намагайтеся уникати прийому проносних, т. к. часте їх використання викликає певну залежність, роблячи дефекацію неможливою без такого стимулу. Не користуйтеся парафиновым (мінеральних) маслом — але перешкоджає засвоєнню вітамінів A, D і E.
- Задумайтеся про оздоровлення кишкової флори з допомогою пробіотиків.
- Щодня випивайте пляшку мінеральної води з магнієм!
- Навіть незначна фізична активність покращує перистальтику кишечника. Привчіть себе щодня ходити пішки не менше години. 2-3 рази на тиждень займайтеся спортом (наприклад, плаванням), і незабаром ви відчуєте себе значно краще.
Терапія синдрому роздратованого кишечника
її рівень pH дорівнює 1,2 (проти 7,4 для інших частин організму) дозволяє знищити все, що потрапляє в зону досяжності. Оскільки завдяки цьому соку відбувається нормальний процес травлення, в ході якого необхідні поживні речовини засвоюються в організмі, одним з головних показників нормальної роботи шлунка буде концентрація кислоти в шлунковому соку, тобто кислотність.
Багатьом здається, що варто припинити харчуватися під час перерви гамбургерами з картоплею фрі і кетчупом, і нормалізується кислотність, а болі в шлунку пройдуть. Але, на жаль, все не так просто.
Кращий компонент ароматерапевтичного лікування цієї хвороби шлунково-кишкового тракту: базилік або естрагон.
Для прийому всередину:
- Капніть 1 краплю базиліка або ефірного масла естрагону в чайну ложку меду і розчиніть в чашці з нас тоем солодки та/або вербени. Приймайте 2-3 р аза в день.
Для зовнішнього застосування при лікуванні цієї хвороби органів ШЛУНКОВО-кишкового тракту:
- Змастіть хворобливу область 2-3 краплями ефірного масла естрагону і втирайте масажними рухами.
Для прийому всередину змішайте:
- Ефірна олія м’яти перцевої 1 краплю
- Ефірне масло базиліка 1 краплю
- Ефірне масло коріандру 1 краплю
Капніть 3 краплі суміші на 1 таблетку з нейтральним вмістом (плацебо), в 1/2 кавової ложечки цукру або 1 кавову ложечку оливкової олії і приймайте 2-3 рази на день після їжі до повного зникнення відчуття печіння в шлунку.
Для масажу при регулярних болях у шлунку змішайте:
- Ефірне масло естрагону 10 крапель
- Ефірна олія м’яти перцевої 10 крапель
- Ефірне масло майорану 10 крапель
- Горіхового Масла 20 мл
Щодня масажними рухами втирайте в область шлунка, вище зони больових відчуттів.
Для лікування цього захворювання шлункового тракту попросіть фармацевта виготовити желатинові капсули з наступним складом:
- Ефірної олії коріандру посівного 20 мг
- Ефірної олії пупавки благородної 10 мг
- Ефірного масла базиліка запашного 10 мг
- Ефірної олії м’яти перцевої 10 мг
- Ефірної олії майорану 20 мг
- Ефірної олії лаванди лікарської 10 мг
Приймайте по 1 капсулі 2-3 рази на день після їжі.
- Увага: якщо ви гіпертонік, то солодка (солодковий корінь) вам протипоказана, хоча вона й дуже корисна для шлунка.
- Чим більше жувальних рухів ви робите, тим менша кислотність шлункового соку, що виробляється вашим шлунком.
- Стрес, кава, алкоголь, жирна їжа і тютюн сприяють підвищенню кислотності шлункового соку. Бережіть себе!
- Прийом протизапальних засобів і аспірину завдає значної шкоди слизовій оболонці шлунка. Приймайте ці препарати тільки під час їжі.
- Стакан глинистої води вранці помітно полегшить біль у шлунку. Увечері перед сном розведіть глину в склянці води і дайте настоятися до ранку. Вранці, не встаючи з ліжка, випийте її.
- Якщо ви проходите курс лікування препаратами на основі ефірних олій, зокрема желатиновими капсулами для орального застосування, то приймайте їх під час або наприкінці прийому їжі, але в жодному разі не натщесерце.
Нижче описано, як в домашніх умовах лікувати таку проблему ШКТ, як жовчнокам’яна хвороба.
Якщо у вас з’явилися спазми товстого кишечника або ободової кишки, значить, ви стали жертвою так званої функціональної колопатии, одним з проявів якої є синдром роздратованого кишечника.
При цьому хворі скаржаться на дискомфорт і біль у животі (справа, зліва, в центрі), або частий рідкий стілець, здуття живота через скупчення газів (що не підтверджується при медичному огляді), відчуття неповного випорожнення кишечника, головний біль і тягнучі болі в області попереку.
Показово, що цей синдром охоплює 15-20% жінок і 5-18% чоловіків.
Що стосується жінок, то згідно зі світовою статистикою синдромом роздратованого кишечника страждають 9 з 10 звернулися пацієнток.
Крім того, синдром подразненого кишечника посилюється при настанні менструацій і нерідко помилково діагностується як фіброміалгія.
Всі ці ознаки виникають внаслідок якогось поштовху і можуть тривати декілька місяців, значно знижуючи якість життя, в тому числі професійної.
Якщо вищевказані болю і порушення супроводжуються запаленням кишечника, значить, у вас коліт.
Базовий компонент ароматерапевтичного лікування цієї кишкової хвороби: естрагон.
Для прийому всередину та для масажу:
- Капніть 1 краплю чистого ефірного масла під язик або на шматочок цукру і тримати у роті до повного розсмоктування або змастіть 2 краплями олії живий від і втерти легкими рухами. Повторіть 2-3 рази в день.
- Ефірне масло коричника цейлонського 1 краплю
- Ефірне масло естрагону 1 краплю
- Ефірне масло коріандру 1 краплю
Отриману суміш для лікування даного кишкового розладу додайте ложку оливкової олії або меду і приймайте 20 днів в місяць вранці, вдень і ввечері після їжі.
- Ефірне масло естрагону 1 краплю
- Ефірне масло материнки 1 краплю
- Ефірне масло пупавки благородної 1 краплю
- Горіхового Масла 3 краплі
Отриманою сумішшю змащуйте область живота 2-3 р аза на день до покращення стану.
- Як показує практика, щоб лікувати це кишкове захворювання, настійно рекомендується прийом відповідних пробіотиків. Якщо ваш кишечник дає про себе знати протягом декількох років, можливо, необхідно відновити кишковий бар’єр. Це тривалий процес, але гра варта свічок.
- Почуття дискомфорту в кишечнику добре знайоме більшості людей з підвищеною тривожністю і тим, хто стурбований власним здоров’ям. Пройдіть необхідний курс лікування, наведіть свій організм в порядок і заспокойтеся.
- Часті запори є основним проявом порушення транзиту в кишечнику. Тому споживайте якомога більше рослинної їжі (фруктів, овочів, цілісних зернових), випивайте не менше 1 літра води в день і, що найголовніше, змусьте себе щодня виконувати хоча б мінімальні фізичні навантаження (ходити пішки, підніматися по сходах і т. п.). Також рекомендуються заняття спортом: плавання, теніс, велоспорт, — будь-яка активність піде вам на користь!
Лікування жовчнокам’яної хвороби
Камені в жовчному міхурі являють собою конкременти, що утворюються в жовчних протоках з холестерину (що не має ніякого зв’язку з холестерином в крові) і кальцію. Вони викликають біль у правій частині живота, запалення жовчного міхура та/або жовтяницю.
У деяких випадках необхідно хірургічне втручання, але, як правило, хвороба проходить майже безсимптомно, і людина навіть не підозрює про наявність каменів у жовчному міхурі. Зрозуміло, якщо камені не турбують, то лікування не проводиться.
У разі якщо вони заподіюють біль або жовчний міхур є вогнищем запалення, або жовчнокам’яна хвороба ускладнюється іншими супутніми захворюваннями, то все-таки необхідно звернутися до лікаря.
Щоб краще уявляти собі, як утворюються камені, потрібно зануритися в глибини нашого організму, а саме — в на ш славний жовчний міхур, який без перепочинку концентрує і накопичує жовч, що виробляється печінкою.
Не найприємніша робота, між іншим. Жовч, будучи травної рідиною, що складається з холестерину, жовчних пігментів і солей, може «кристалізуватися» в результаті зміни свого складу або присутності мікробів. Ось так в жовчному міхурі і з’являються камені.
Базовий компонент ароматерапевтичного лікування даного порушення ШКТ: аммі зубна або виснага.
Для зовнішнього застосування:
- Наносити по 2 краплі на область печінки кожні півгодини аж до помітного поліпшення.
Для зовнішнього застосування змішайте:
- Ефірне масло аммі зубної 2 краплі
- Ефірне масло базиліка 1 краплю
- РМ рододендрона гренландського 1 краплю
Нанесіть, як було зазначено вище.
Для лікування цього порушення шлунково-кишкового тракту змішайте:
- Ефірна олія м’яти перцевої 1 краплю
- Ефірне масло базиліка 1 краплю
- Ефірне масло розмарину вербенонового 1 краплю
- Есенції лимона 1 краплю
Нанесіть на 1 нейтральну таблетку, додайте в маленьку ложку меду або рослинного масла і тримати у роті до повного розсмоктування через кожні 15 хвилин протягом 1 години.
- При лікуванні цього шлункового захворювання настійно рекомендується пити відвар кори липи — 1 літ р в день протягом місяця. Для цього достатньо покласти 5 паличок кори липи в 1 літ р води, довести до кипіння і кип’ятити протягом 5 хвилин із закритою кришкою. Вимкніть вогонь і дайте настоятися протягом 10 хвилин. Випийте протягом 24 годин, додавши у відвар кілька крапель лимонного соку. Зрозуміло, без цукру!
- Жовчнокам’яна хвороба набагато частіше зустрічається у жінок, чим у чоловіків. Насамперед вона обумовлена зайвою вагою, діабетом і багаторазовими вагітностями, які, ймовірно, сприяють литиазу — утворення каменів у жовчному міхурі. Свою роль грає спадкова схильність, а також вживання деяких медикаментів — таких, наприклад, як клофібрат, істотно збільшує ризик розвитку хвороби. Боротьба із зайвою вагою одночасно є і боротьбою з жовчнокам’яною хворобою: на кожен 1 кг зайвої ваги наш організм виробляє 20 мг холестерину, і чим менше буде «обсяг виробництва», тим корисніше для здоров’я!
- Намагайтеся під що б то ні з тало уникати переїдання — краще їсти менше, але частіше. Невеликі за обсягом, але більш часті прийоми їжі допомагають жовчного міхура швидше виводити небажані речовини з організму.
- Рекомендується помірне харчування із включенням у раціон жирної риби (лосось, скумбрія, тунець), фруктів, овочів, цільнозернових продуктів і рясне пиття води.
Далі ви дізнаєтеся, як лікувати таке захворювання ШКТ, як запор.